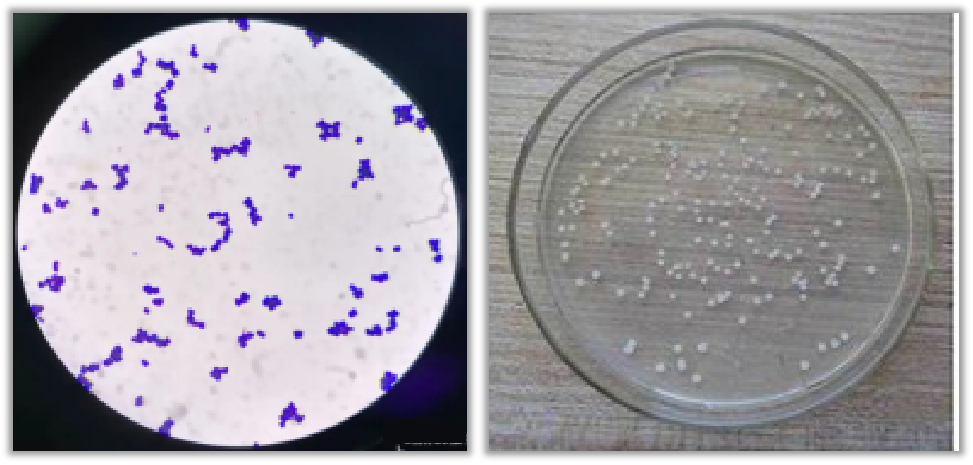
图片

生活中,很多人喜欢吃腐乳。腐乳是豆腐坯经微生物发酵,再用盐和各种香料腌制而成。因其味道独特,营养价值较高,深受人们的喜爱。但你们可曾想过,在腐乳发酵过程中,长出的那一层毛绒绒的霉菌,到底是什么菌?对人体有害吗?
腐乳的加工工艺一般经过浸泡、磨浆、过滤、煮浆、点浆、蹲脑、凝固、压榨切块、前期发酵、搓毛腌制、后期发酵等过程。但其中比较重要的环节是发酵。


腐乳一般采用微生物发酵。微生物发酵主要是将大豆中的蛋白质水解。不同种植地的大豆品种不一,使腐乳中的营养物质也比较丰富, 主要有蛋白质、氨基酸、糖类、植酸、游离脂肪酸及维生素等。

其中微生物发酵主要分为毛霉发酵、根霉发酵及细菌发酵。
毛霉的种类主要有雅致放射毛霉、五通桥毛霉、总状毛霉、高大毛霉和腐乳毛霉等,常用于腐乳的发酵。毛霉能产生蛋白酶和脂肪酶,其中蛋白酶产量较大,使腐乳具有鲜味的蛋白质分解物。毛霉菌丝发达,有利于发酵,能保证腐乳口感细腻有质地,使腐乳坯变得柔嫩,营养成分易于消化吸收。但毛霉的生长温度一般在 15 ~ 25 ℃,不利于夏季生产发酵。
▼ 毛霉

根霉的种类主要有因米根霉、华根霉、无根霉等,因其与毛霉亲缘性较高,也常用于腐乳的发酵。根霉较毛霉更耐高温,生长温度域更宽,不受季节限制。根霉分泌的淀粉酶活性很强,可糖化淀粉生产酒精。除此之外,在后期发酵中,还可利用根霉的糖化淀粉作用产生的少量乙醇、乳酸等,丰富腐乳的风味。而且根霉还可分泌脂肪酶等其他酶系,分解产生更多的营养物质。
细菌在腐乳的发酵过程中发挥的作用与毛霉根霉相似,但发酵周期较长。日常生产中,常用的腐乳发酵菌种主要有微球菌和枯草芽孢杆菌。
微球菌可产生脂肪酶、谷氨酰胺酶等酶类。谷氨酰胺酶具有很好的耐盐性,有利于高盐条件下的腐乳发酵,且谷氨酰胺酶可转化出L- 谷氨酸,为腐乳发酵提供更鲜美的风味。枯草芽孢杆菌具有非致病性、分泌蛋白能力强等特点,可为腐乳发酵提供良好的物质基础,使腐乳发酵得更加彻底。
▼ 枯草芽孢杆菌

▼ 微球菌
腐乳的检测标准为GB2712-2014《食品安全国家标准 豆制品》 ,其检测项目及限量值如下:


虽说腐乳是个相对健康的食物,但是也并不适合所有人,对于这四类人群而言,劝你最好少吃腐乳。
高血压患者日常需要限制盐分摄入,日均用盐量应控制在5g以内,大量食用腐乳容易导致钠元素摄入超标,对于血压控制不利。
腐乳的原材料黄豆属于高嘌呤食物,对于高尿酸、痛风的类人群而言显然不是个好选择,大量食用腐乳容易导致体内尿酸水平升高。
幽门螺杆菌感染合并胃炎人群也不适宜食用腐乳。幽门螺杆菌特别喜欢在高钠环境下生殖繁衍,大量食用腐乳无疑是在给幽门螺杆菌的繁殖提供便利条件。
婴幼儿的饮食需要限制盐分摄入,所以不建议食用腐乳。
对于普通人而言,日常也要限制腐乳的摄入量,大量食用腐乳容易导致钠含量摄入超标,对于健康不利。
日常储存腐乳要注意在低温环境下,吃不完的腐乳及时拧紧瓶盖,不要用不干净的筷子夹腐乳,注意饮食安全,防止腐乳被细菌感染,发生变质。

综上所述,对于大部分的人群而言,日常适当食用腐乳不会对人体健康有害,但要注意适量。